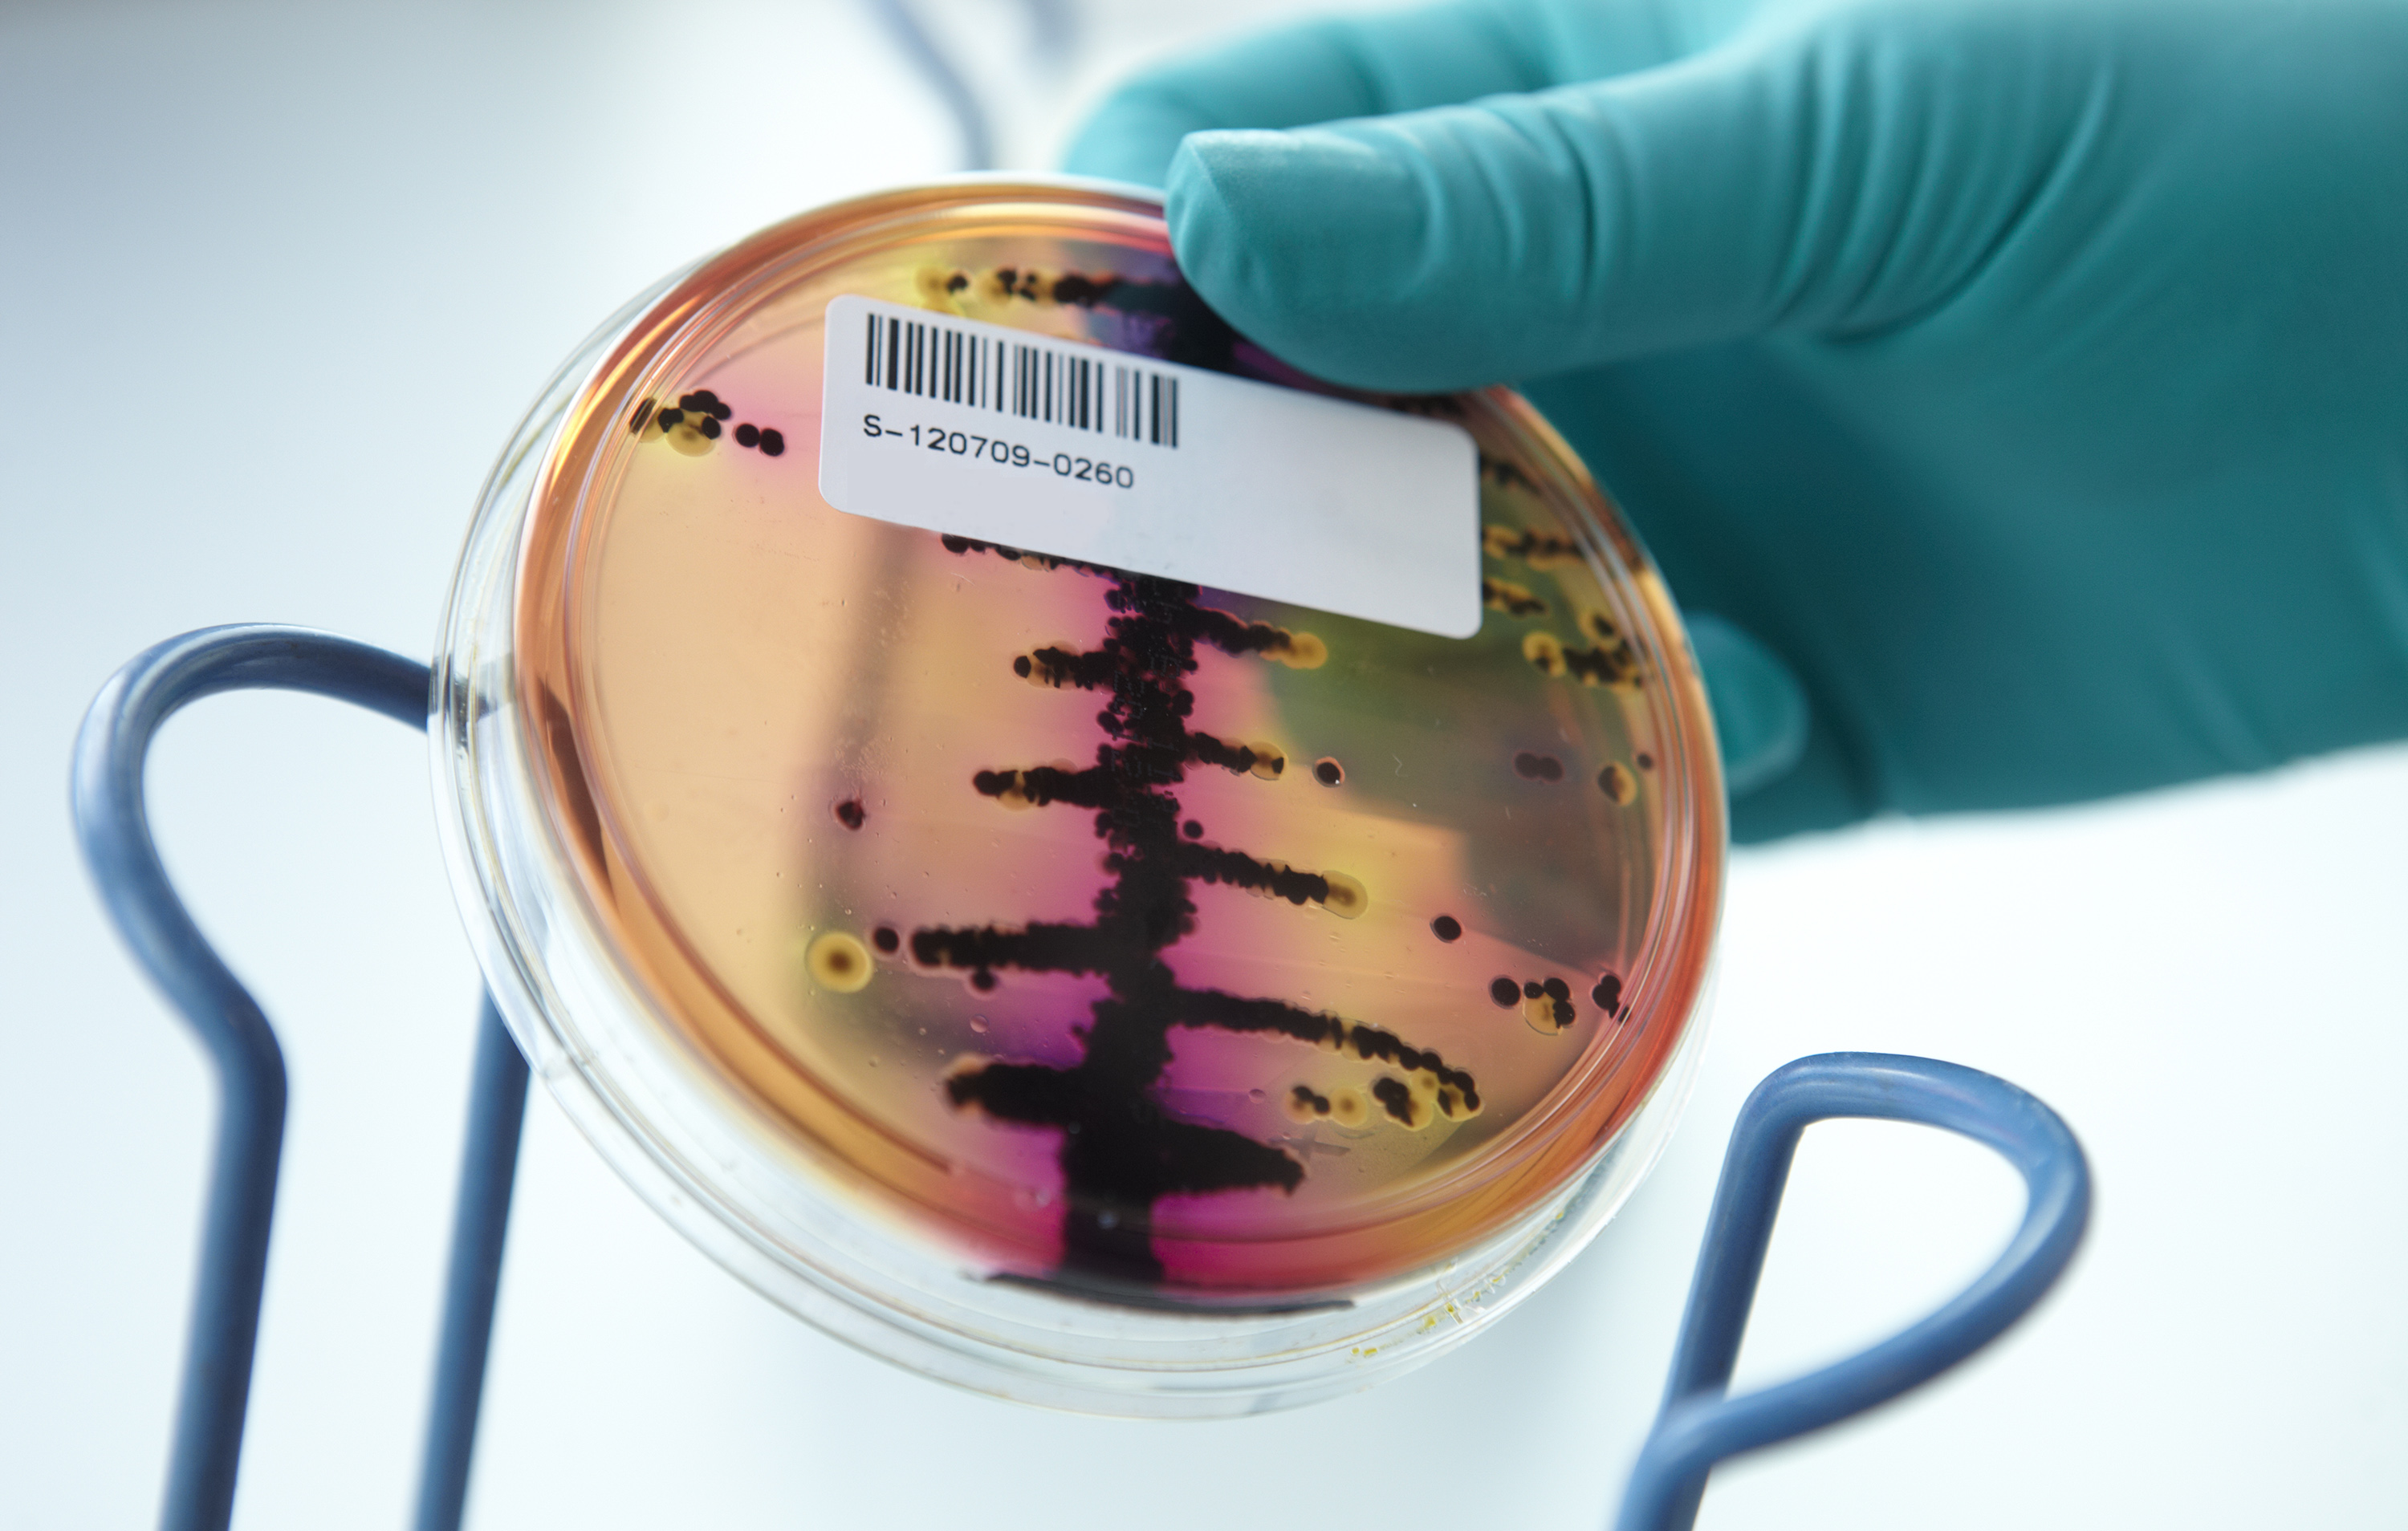
Laboratorieundersoegelse

Hvad sker der, hvis en dansk besætning bliver ramt af afrikansk svinepest? Det blev der sat fokus på i indlægget ”Breaking: Ramt af svinepest” på sidste års Svinekongres. Her blev hele processen lavet som en form for teater, hvor alle interessenter var med – fra svineproducenten selv til Fødevarestyrelsen.
Indlægget var så populært, at flere ville se videoen derfra. Det har ikke været muligt, men til gengæld er der i stedet lavet en podcast på 30 minutter som et sammenkog på denne populære session.
Du kan hente podcast'en gratis i din podcast-app: Søg på ”SEGES Podcast” - "Den dag svinepesten kom til gården" - eller bruge linket nedenfor.